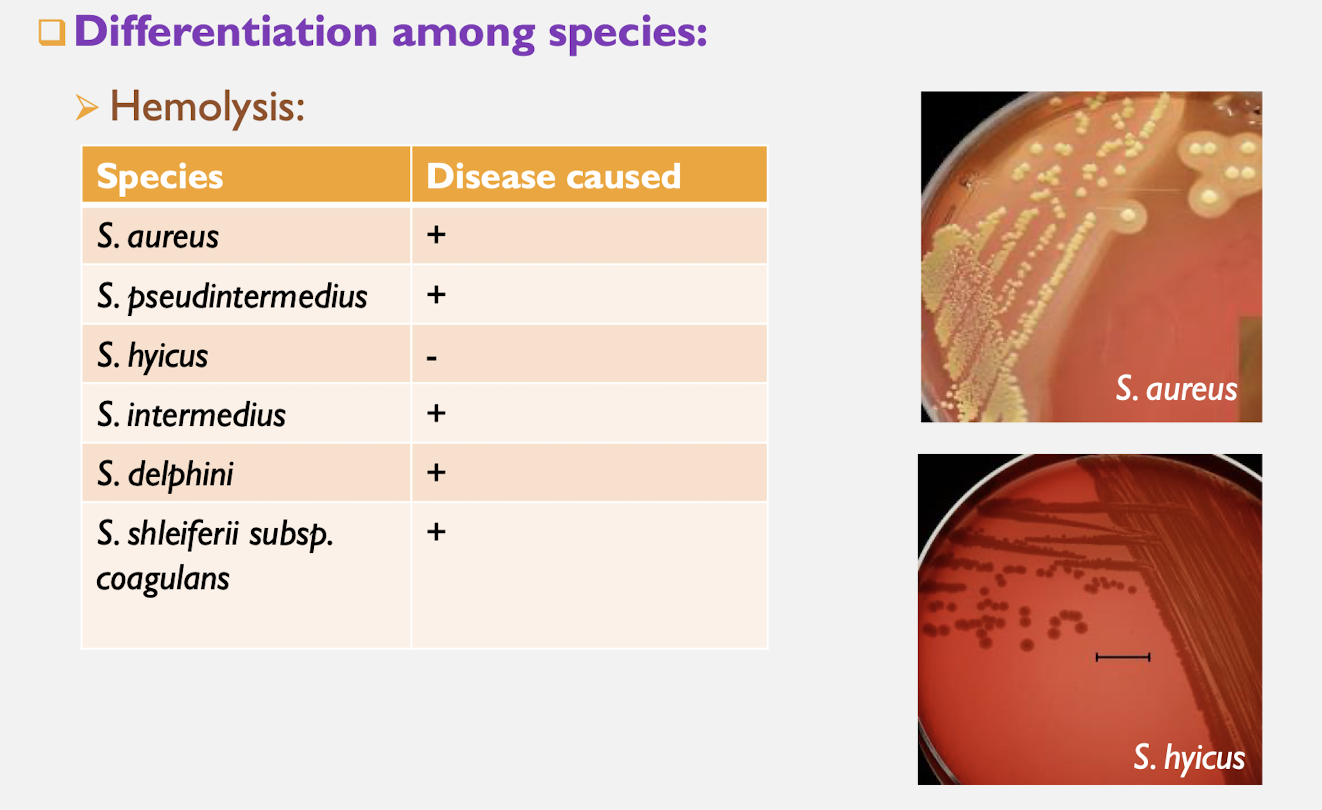

what are the general characteristics of all staphylococcus?
gram-positive cocci
catalase positive
where are commensal staphylococcus found?
skin and mucous membrane
How do opportunistic staphylococcus cause infection?
pyogenic infection by damage to skin or MM, immunocompromised patients
what are tests that can be used to differentiate between staphylococcus species?
coagulase
colony color
hemolysis
what is a positive and negative result of coagulase test indicative of with staphylococcus?
positive - pathogenic strains
negative - non-pathogenic strains
What is a staphylococcus species that causes hemolysis indicate?
causes disease
what are virulence factors present with staphylococcus?
adhesins
protein A
toxins
invasins
urease ( S. pesudintermedius)
what are adhesins?
facilitate bacterial attachment to host tissues
what is protein A?
virulence factor that interferes with opsonization and phagocytosis
what does alpha-toxin (alpha-hemolysin) do?
complete lysis of RBCs
spasm of smooth muscle
what does beta-toxin (beta-hemolysin) do?
incomplete/partial lysis of RBC
what does gamma-toxin (leucocidin) do?
cytolytic destruction of leukocytes
what enterotoxins do staph produce? what does it lead to?
enterotoxin A-E and G-J, SEA-SEJ, superantigen
food poisoning
which bacteria secrete toxins and which release?
secrete - exotoxins
release - endotoxins
what is a superantigen?
binds non-specifically to MHC-II and T cell receptor, leads to massive T cell activation
what is TSST-I?
toxic shock syndrom toxin - I
toxic shock when released into blood
superantigen
what is an exofoliative toxin?
proteases that exfoliate onto skin
what staphylococcus cases exudative epidermitis in pigs? what does this?
S. hyicus
exfoliative toxins
what are invasins?
enzymes that contribute to tissue destruction
what are some invasins that staph produce? what do they do
staphylokinase - break down blood clot
hyuluronidase - depolymerizes hyaluronic acid (CT)
capsule - protects bacterial cells from phagocytosis
what does S. pseudointermedius urease do?
raise pH of urine
possible formation urinary stones - urolithiasis
what is the causative agent of mastitis in cattle?
staphylococcus aureus
where is the main source of infection with mastitis?
udder
what virulence factors contribute to mastitis?
adhesins, invasins, capsule, leukocidin, hemolysins, exotoxins
toxins cause tissue damae








